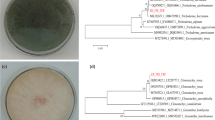

Abstract
We previously identified Mitsuaria sp. TWR114 and nonpathogenic Ralstonia sp. TCR112 as potential biocontrol agents to suppress tomato bacterial wilt caused by Ralstonia pseudosolanacearum. Because commercial biocontrol products require a practical cost-effective application method that maximizes their performance, we investigated whether the combined application of TWR114 and TCR112 enhances the biocontrol of bacterial wilt. In pot experiments, all the tested inoculum ratios (i.e., 1:1, 1:2, and 2:1) of the TWR114 + TCR112 treatment significantly suppressed the incidence of bacterial wilt, even at 28 days post-challenge inoculation (dpi) (13–47% wilt incidence), while 60% of plants treated with the individual isolates developed bacterial wilt within 10–12 dpi. The pathogen population in the rhizosphere and aboveground regions decreased considerably after the TWR114 + TCR112 treatment compared with that in the individual treatments. Moreover, the pathogen population in the aboveground parts of TWR114 + TCR112-treated plants had decreased to an undetectable level by 28 dpi. After inoculation with the pathogen, the expression of several tomato defense-related genes was higher in the TWR114 + TCR112-treated plants than in those treated with the individual isolates. Altogether, the results indicate that TWR114 and TCR112 applied together have a synergistic suppressive effect and that stronger defense priming might contribute to the improved biocontrol. The combination of both isolates may be a very promising approach for controlling tomato bacterial wilt in the future.
Similar content being viewed by others
Avoid common mistakes on your manuscript.
Introduction
Bacterial wilt caused by the soil-borne pathogens Ralstonia solanacearum (Yabuuchi et al. 1995), R. pseudosolanacearum and R. syzygii subsp. indonesiensis (Safni et al. 2014) is ranked as the second most destructive bacterial disease of plants worldwide (Mansfield et al. 2012). Together, these pathogens infect more than 200 plant species among more than 50 different plant families, including important solanaceous crops such as tomato (Solanum lycopersicum L.), potato (S. tuberosum L.), tobacco (Nicotiana tabacum L.), eggplant (S. melongena L.), and Capsicum spp. Direct crop losses can reach up to 90% in tomato and potato and 70% in tobacco (Elphinstone 2005). Pathogenic Ralstonia bacteria penetrate roots via natural openings and wounds, then move into the xylem vessels where they block the translocation of water, resulting in wilting and subsequently death of the plants (Álvarez et al. 2010).
Although bacterial wilt has been controlled using antagonistic bacteria (Boukaew et al. 2011; Chen et al. 2014; Xue et al. 2009; Yamamoto et al. 2015), most studies have involved a single biocontrol agent (BCA) in pots and/or field experiments. Yuliar and Toyota (2015) pointed out that the biocontrol effect of single BCAs can sometimes be low and/or short-lasting, thus requiring uneconomically high rates of inoculum or repeated applications in the field. They considered that these points are the most important disadvantages of BCAs in controlling bacterial wilt. Therefore, more sophisticated methods are required to improve the biocontrol of wilt disease. The combined use of several BCAs to control plant diseases was proposed as an effective way to overcome some of these drawbacks (Spadaro and Gullino 2005) and to exploit potential synergistic effects that may promote plant health (Sarma et al. 2015; Xu et al. 2011).
Many previous studies reported that the combined application of multiple microbes enhance the biocontrol efficacy and reliability against bacterial wilt on tomato, tobacco, bell pepper (Capsicum annuum L.), and Coleus (Coleus forskohlii Briq.) plants (Jetiyanon 2007; Jetiyanon and Kloepper 2002; Liu et al. 2013, 2014; Singh et al. 2013; Yuan et al. 2016). Such combinations have also provided broad-spectrum protection against multiple pathogens (Domenech et al. 2006; Jetiyanon et al. 2003; Raupach and Kloepper 1998) and improved the growth, yield, and quality of different crops (Lucas et al. 2009; Santiago et al. 2017; Srivastava et al. 2010).
Recently, we identified Mitsuaria sp. TWR114 and nonpathogenic Ralstonia sp. TCR112, originally isolated from Welsh onion (Allium fistulosum L.) and Chinese chives (A. tuberosum Rottler ex Spreng), respectively, as potential BCAs capable of suppressing tomato bacterial wilt (Marian et al. 2018). In a previous study, we reported that a single application of these individual isolates effectively suppressed bacterial wilt for up to 2 weeks in tomato plants in a glasshouse. Moreover, weekly drenching with each of these two isolates provided considerable protection of field-grown tomatoes against bacterial wilt. However, to commercialize our isolates as practical biocontrol products, we need a cost-effective application method to maximize their biocontrol performance. Therefore, in the present study, we investigated whether the combined application of TWR114 and TCR112 enhances the biocontrol effect against tomato bacterial wilt.
Materials and methods
Bacterial isolates, culture conditions, and inoculum preparation
The biocontrol bacteria TWR114 and TCR112 and the pathogen R. pseudosolanacearum isolate VT0801 were used throughout this study (Marian et al. 2018). The TWR114 and TCR112 isolates were cultured in nutrient broth (Nissui Pharmaceutical, Tokyo, Japan). Isolate VT0801 was cultured in casamino acid–peptone–glucose broth (Hendrick and Sequeira 1984). All cultures were incubated at 30 °C for 24 h with shaking at 200 rpm. The cells of TWR114 and TCR112 were harvested by centrifugation at 10,000 rpm for 10 min, washed twice and resuspended in sterile distilled water (SDW) to a final concentration of ca. 9 × 108 colony forming unit (CFU)/ml. The cells of VT0801 was harvested as mentioned earlier, washed twice and resuspended in 10 mM MgCl2 to a final concentration of ca. 2 × 107 CFU/ml.
Growth conditions of tomato plants
Seeds of tomato (cv. Ponderosa, susceptible to bacterial wilt) were surface-sterilized with 70% (v/v) ethanol for 1 min, followed by 1% (v/v) sodium hypochlorite for 5 min and then thoroughly rinsed with SDW. After germination on a moist filter paper, the seeds were sown in plastic trays (Bee pot Y-49; Canelon Kaka, Japan) containing a commercial potting soil mix Saika Ichiban (Ibigawa Kogyo, Japan) and grown in a glasshouse (maintained at 30 °C, relative humidity of 70%) until the seedlings reached the four-leaf stage. Tomato seedlings were then transplanted into vinyl pots (9 cm in diameter) comprising three layers: top and bottom layers, each containing 150 g of commercial potting soil mix; and a middle layer, containing 20 g of river sand. For biocontrol experiments and bacterial enumeration, the tomato plants were grown in the same glasshouse. For the analysis of defense-related genes, the plants were grown in a chamber with a controlled environment (Biotron, standard model LH-241SP; Nippon Medical and Chemical Instruments, Osaka, Japan) at 28 °C and a 12-h light/12-h dark cycle.
Evaluation of biocontrol effect of combined application of TWR114 and TCR112 in pot experiments
Effect of inoculum ratios
For the TWR114 + TCR112 treatment, cell suspensions of TWR114 and TCR112 (ca. 9 × 108 CFU/ml) were mixed thoroughly at ratios of 1:1, 1:2, and 2:1 (v/v), before the treatment of tomato plants by bottom watering (100 ml/pot). For individual treatments, a cell suspension of each isolate was applied (100 ml/pot) to obtain a final concentration of 3 × 108 CFU/g wet soil. Control plants were treated with an equal volume of SDW without the bacteria. Three days after treatment (dat), all plants were challenged with 100 ml of a washed cell suspension of VT0801 to obtain a final concentration of 7 × 106 CFU/g wet soil. The inoculated plants were maintained in the glasshouse for 28 days. Each treatment had five plants, and the experiment was repeated three times.
Effect of inoculum concentration
Plants were treated with the combination of TWR114 and TCR12 (100 ml/pot) at a ratio of 2:1 (v/v, selected from the above pot experiment) using the original inoculum concentration (ca. 9 × 108 CFU/ml) or twofold (ca. 4.5 × 108 CFU/ml) or tenfold (ca. 9 × 107 CFU/ml) dilutions of the original concentration. The plants treated with an equal volume of SDW were used as controls. At 3 dat, all plants were challenged with the pathogen as mentioned above. The inoculated plants were maintained in the same glasshouse for 28 days. Each treatment included five plants, and the experiments were repeated three times.
Disease assessment
The number of wilted plants was recorded daily, and disease incidence and the area under the disease progress curve (AUDPC) were calculated using the following formulas:
AUDPC = ∑ [0.5(xi+1 + xi)](ti+1 − ti), where xi+1 and xi are disease incidence at times ti+1 and ti, respectively, and ti+1 and ti are consecutive evaluation dates, with ti+1 and ti equal to 1.
Quantification of R. pseudosolanacearum
Tomato plants were treated with the combination of TWR114 and TCR112 at a ratio of 2:1 using the original inoculum concentration (ca. 9 × 108 CFU/ml), or with the individual isolates and then challenged with R. pseudosolanacearum VT0801 as described in the above pot experiments. The pathogen multiplication in the rhizosphere soil, crown (basal part of hypocotyl), mid-stem (immediately above the cotyledon), and upper stem (approximately 1 cm above the first true leaves) of plants without wilt symptoms was determined at 1, 3, 5, 7, and 28 days post-challenge inoculation (dpi). Samples were obtained from three plants that were treated with TWR114 + TCR112 and the individual isolates and an untreated control at each time point. The rhizosphere soils tightly attached to the roots were harvested and serially diluted with SDW. The aboveground samples (crowns, mid-stems, and upper stems; each 2 cm long) of tomato plants were surface-sterilized with 100% ethanol and flamed for 5 s as described previously (Marian et al. 2018). The samples were then homogenized using a sterile mortar and pestle, and used to prepare serial dilutions in SDW. Dilutions of rhizosphere soil and tissue homogenates were spread onto triplicate plates of modified semi-selective medium South Africa (French et al. 1995). Typical colonies of R. pseudosolanacearum that appeared elevated and fluidal with a pink center were counted after incubation for 3 days at 30 °C. The experiment was repeated three times. The size of the bacterial populations was expressed as log colony-forming units per gram (wet mass) of soil (log CFU/g wet soil) or tissue (log CFU/g fresh tissue).
Quantification of TWR114 and TCR112 isolates
The populations of TWR114 and TCR112 in the rhizosphere and aboveground (crown, mid-stem, and upper stem) regions of tomato plants were also enumerated by spreading the same dilutions of the rhizosphere soils and tissue homogenates used for the pathogen enumeration in triplicate onto isolation media that were optimized for each isolate, as described previously (Marian et al. 2018). These inoculated plates were incubated at 30 °C for 48 h, and the colonies were counted (Marian et al. 2018). The experiment was repeated three times.
In vitro compatibility test between TWR114 and TCR112 isolates
Both biocontrol isolates were tested for their compatibility with each other using the agar well diffusion assay. Three milliliters of the TWR114 or TCR112 washed cell suspension was added to 100 ml of molten King’s B agar and poured into square Petri dishes (100 × 100 mm). After agar solidification, 7 mm diameter wells were cut out using a sterile cork borer, and 70-µl of culture broth of TWR114 or TCR112 isolate was added to each well. The inhibition of TWR114 and TCR112 growth was assessed based on the production of a clear halo zone surrounding the wells. Three replicates were used for each bacterial isolate.
Analysis of tomato defense-related gene expression using quantitative real-time PCR
Tomato plants were treated with the 2:1 combination of TWR114 and TCR112 or TWR114 or TCR112 alone, then challenged with R. pseudosolanacearum VT0801 as described for the pot experiments. The main root (100 mg) was sampled from plants inoculated with the pathogen or none at 5 dat (2 dpi) and 7 dat (4 dpi) to analyze expression of PR-1a and GluA, GluB and Osmotin-like, Le4, and LoxD, which are related to the salicylic acid (SA), ethylene (ET), abscisic acid (ABA), and jasmonic acid (JA) signaling pathways, respectively.
RNA was extracted from samples that were powdered in liquid nitrogen as described previously by Suzuki et al. (2003) with slight modifications and extraction buffer (2% [w/v] of cetyltrimethylammonium bromide, 100 mM of Tris–HCl [pH 6.8], 25 mM of EDTA [pH 8.0], 1.4 M of NaCl, and 5% [v/v] of 2-mercaptoethanol added just before use and heated at 65 °C for 10 min). The resulting upper aqueous phase from centrifugation was re-extracted with a chloroform–isoamyl alcohol mixture (24:1, v/v). The collected supernatant was extracted with water-saturated phenol, guanidium thiocyanate, sodium acetate (pH 4.0) and chloroform. The upper phase was precipitated with isopropanol. The precipitated RNA was collected, washed twice with 75% ethanol, air dried briefly and dissolved in RNase-free water. RNA concentrations were measured with a NanoVue Plus Spectrophotometer (GE Healthcare Life Sciences, UK).
Five hundred nanograms of total RNA were used to synthesize the first-strand cDNA by ReverTra Ace qPCR RT Master Mix with a gDNA Remover (Toyobo, Osaka, Japan), following the manufacturer’s protocol. The reverse transcription products (10 µl) were diluted with an equal volume of RNase-free water (water deionized and sterilized; Nacalai Tesque, Kyoto, Japan) and used as templates for quantitative real-time PCR (qRT-PCR), performed using SYBR Premix Ex Taq II (Tli RNaseH Plus; Takara Bio, Otsu, Japan). The qRT-PCR reaction mixtures were prepared in a total volume of 10 µl containing 3 µl of RNase-free water, 5 µl of 2× SYBR Premix, 1 µl of the cDNA template, and 0.5 µl of 10 µM of each forward and reverse gene-specific primer (0.5 µM final concentration). The gene-specific primers used in this experiment are shown in Table 1. The reactions were performed with a LightCycler Nano Instrument (Roche Diagnostics, Mannheim, Germany) using an initial denaturation step of 95 °C for 30 s, followed by 45 cycles of a three-step amplification profile of denaturation at 95 °C for 10 s, primer annealing at 60 °C for 10 s, and extension at 72 °C for 60 s. The specific amplification was verified by melting curve analysis run from 60 to 97 °C at the end of each qRT-PCR. The housekeeping gene β-tubulin was used for normalization. The expression level of the target genes in different samples was calculated using the formula 2−ΔΔCT (Livak and Schmittgen 2001) and given as a value relative to the untreated control plants (not inoculated with the pathogen). The qRT-PCR experiment was conducted once with three biological replicates for each treatment and three technical repetitions for each replicate.
Statistical analyses
Differences among treatments in the biocontrol studies and analysis of defense gene expression were analyzed using Tukey’s multiple-comparison test (P < 0.05). Population data for the pathogen and biocontrol bacteria were transformed into logarithmic values then analyzed using Tukey’s multiple-comparison test (P < 0.05) and Student t-test (P < 0.05), respectively. Throughout the bacterial population studies, the minimum detection limit was 2.5 log CFU/g wet soil and 1.5 log CFU/g fresh tissue in the rhizosphere and aboveground regions, respectively. All analyses were performed using BellCurve for Excel (version 2.13; Social Survey Research Information, Tokyo, Japan).
Results
Biocontrol effect of combined application of TWR114 and TCR112 in pot experiments
When different ratios of TWR114 + TCR112 were tested on plants in a glasshouse, all ratios (i.e., 1:1, 1:2, and 2:1) significantly suppressed the incidence of bacterial wilt even at 28 dpi (13–47% wilt incidence), whereas the incidence of bacterial wilt on plants treated with the individual isolates surpassed 60% within 10–12 dpi (Figs. 1, 2a). Among the three ratios, 2:1 was associated with the greatest reduction (93%) in AUDPC for wilt incidence (Fig. 2b).
Effects of applications of Mitsuaria sp. TWR114 and nonpathogenic Ralstonia sp. TCR112 at different inoculum ratios on tomato bacterial wilt at 28 days post inoculation with Ralstonia pseudosolanacearum. a Untreated control. b TWR114. c TCR112. d TWR114 + TCR112 (ratio 1:1). e TWR114 + TCR112 (ratio 1:2). f TWR114 + TCR112 (ratio 2:1)
Effect of inoculum ratios of the combined application of Mitsuaria sp. TWR114 and nonpathogenic Ralstonia sp. TCR112 on incidence of bacterial wilt in tomato plants grown in a glasshouse. a Disease incidence over time after different treatments post inoculation with Ralstonia pseudosolanacearum. b Area under the disease progress curve (AUDPC). Bars represent mean ± standard error of three independent experiments. Different letters indicate significant differences among treatments according to Tukey’s test at P < 0.05
When this ratio was further evaluated in another pot experiment, all tested concentrations (i.e., original concentration, twofold dilution, and tenfold dilution) of the 2:1 TWR114 + TCR112 significantly reduced disease incidence, with the original concentration (ca. 9 × 108 CFU/ml) most effective, achieving the highest reduction (100%) in AUDPC (Fig. 3). Accordingly, the 2:1 TWR114 + TCR112 treatment at the original concentration was used throughout the following experiments.
Effect of inoculum concentration in the combined application at a ratio of 2:1 of Mitsuaria sp. TWR114 and nonpathogenic Ralstonia sp. TCR112 on the incidence of tomato bacterial wilt expressed as area under the disease progress curve (AUDPC). Original concentration: ca. 9 × 108 CFU/ml. Bars represent mean ± standard error of three independent experiments. Different letters indicate significant differences among treatments according to Tukey’s test at P < 0.05
Quantification of R. pseudosolanacearum
We monitored the pathogen population in symptomless plants treated with biocontrol bacteria and untreated control at 1, 3, 5, 7, and 28 dpi. At 28 dpi, all of the plants treated with TWR114 alone, and TCR112 alone and untreated control were completely wilted, and thus pathogen populations in these plants were not investigated. In the rhizosphere of tomato plants, the pathogen population was considerably reduced by the TWR114 + TCR112 treatment and the individual treatments compared with that in the untreated control at 3 and 5 dpi (Fig. 4a). Subsequently, at 7 dpi, the pathogen population reached densities similar to those in the untreated control (ca. 7 log CFU/g wet soil). However, the pathogen population had greatly decreased to less than 4 log CFU/g wet soil in the TWR114 + TCR112 treatment at 28 dpi. The population densities in the aboveground regions of plants treated with TWR114 + TCR112 and individual isolates were significantly lower than in untreated plants at 5 dpi (Fig. 4b–d). At 7 dpi, the populations in the individual treatments reached densities similar to that in the untreated control, whereas in the TWR114 + TCR112 treatment, the population density remained considerably lower than in the untreated control. In the TWR114 + TCR112 treatment, the pathogen population in the aboveground regions was reduced to an undetectable level (< 1.5 log CFU/g fresh tissue) at 28 dpi.
Population dynamics of Ralstonia pseudosolanacearum in tomato plants treated with the combination of Mitsuaria sp. TWR114 and nonpathogenic Ralstonia sp. TCR112 or the individual isolates. a Rhizosphere soil. b Crown. c Mid-stem. d Upper stem. Bars represent the mean ± standard error of three independent experiments. Different letters represent significant differences among treatments according to Tukey’s test at P < 0.05. NT not tested, ND not detected
Quantification of biocontrol isolates TWR114 and TCR112
Both isolates were successfully recovered from all regions (rhizosphere, crown, mid-stem, and upper stem) of tomato plants in the TWR114 + TCR112 treatment and individual treatments during growth in the glasshouse, except at 28 dpi (31 dat), when TCR112 was not detected in the upper stem of TWR114 + TCR112-treated plants (Figs. 5, 6). Throughout the experiment, the population of TWR114 and TCR112 in all treatments was relatively stable in the rhizosphere (6.5–7.5 log CFU/g wet soil and 5.6–7.2 log CFU/g wet soil, respectively) and crown (3.0–4.7 log CFU/g fresh tissue and 1.9–4.0 log CFU/g fresh tissue, respectively) (Fig. 5a, 5b, 6a, and 6b). In the mid-stem, TWR114 and TCR112 persisted at about 3 log CFU/g tissue until 7 dpi (10 dat) (Figs. 5c, 6c). However, at 28 dpi (31 dat), population densities of TWR114 and TCR112 decreased to about 2 and 1 log CFU/g fresh tissue, respectively. Similarly, both isolates established populations of about 1 to 2 log CFU/g fresh tissue in the upper stem until 7 dpi (10 dat), then considerably decreased at 28 dpi (31 dat) (Figs. 5d, 6d). At most sampling times in all regions, the population size of the respective isolates in the TWR114 + TCR112 treatment did not differ significantly from that in the individual treatments (Figs. 5, 6).
Population dynamics of Mitsuaria sp. TWR114 in tomato plants treated with the combination of TWR114 and nonpathogenic Ralstonia sp. TCR112 or with TWR114 alone. a Rhizosphere soil. b Crown. c Mid-stem. d Upper stem. Bars represent mean ± standard error of three independent experiments. An asterisk indicates significant difference between the biocontrol bacterial treatments according to Student’s t-test at P < 0.05. NT not tested, ND not detected
Population dynamics of nonpathogenic Ralstonia sp. TCR112 in tomato plants treated with the combination of Mitsuaria sp. TWR114 and TCR112 or with TCR112 alone. a Rhizosphere soil. b Crown. c Mid-stem. d Upper stem. Bars represent the mean ± standard error of three independent experiments. An asterisk indicates significant difference between the biocontrol bacterial treatments according to Student’s t-test at P < 0.05. NT not tested, ND not detected
In vitro compatibility between TWR114 and TCR112
TWR114 isolate exhibited antibacterial activity against the TCR112 isolate, as evidenced by the presence of an inhibition zone around the well in the agar well diffusion assay, whereas TCR112 isolate did not have any activity against TWR114, as indicated by the absence of any such inhibition zone (Fig. 7).
Induction of tomato defense-related genes by TWR114 and TCR112 treatment
After TWR114 + TCR112 treatment and the treatments with each isolate individually, the expression of the six defense-related genes in the tomato root was determined by qRT-PCR at 5 and 7 dat (2 and 4 dpi, respectively) in pathogen-uninoculated and -inoculated plants. In the absence of the pathogen, the expression of ABA- or ET-responsive marker genes was slightly induced or not present in bacterized plants regardless of the type of treatment, whereas the expression of SA- and JA-responsive genes was strongly induced by the individual treatments compared with the TWR114 + TCR112 treatment (Fig. 8). In pathogen-inoculated plants, the expression of SA-responsive marker genes PR-1a and GluA significantly increased in the TWR114 + TCR112 treatment compared with those in the individual treatments and pathogen-inoculated control at 2 dpi (Fig. 8a, b). The expression of ET-responsive genes GluB and Osmotin-like was considerably increased by TWR114 + TCR112 compared with that in the TWR114 and TCR112 individual treatments and pathogen-inoculated control at 4 dpi (Fig. 8c, d). The expression of the ABA-responsive gene Le4 was strongly induced by the TWR114 + TCR112 treatment and the TWR114 treatment compared with that by the TCR112 treatment and pathogen-inoculated control at 2 dpi (Fig. 8e). The JA-responsive gene LoxD was not induced by any of the treatments (Fig. 8f).
Expression of defense-related genes in tomato plants treated with the combination of Mitsuaria sp. TWR114 and nonpathogenic Ralstonia sp. TCR112, the individual isolates, or no treatment, then inoculated without or with Ralstonia pseudosolanacearum at 5 and 7 days after treatment (dat) (2 and 4 days post-challenge inoculation [dpi], respectively). aPR-1a. bGluA. cGluB. dOsmotin-like. eLe4. fLoxD. The housekeeping gene β-tubulin was used for normalization. The expression level of the target genes in different samples was calculated using the formula 2− ΔΔCT (Livak and Schmittgen 2001), given as a value relative to the untreated control plants (not inoculated with the pathogen). Bars represent the mean ± standard error of three biological replicates per treatment with three technical repetitions for each sample. Different lowercase and uppercase letters indicate significant differences between treatments according to Tukey’s test at P < 0.05
Discussion
To establish a cost-effective method for applying the isolates Mitsuaria sp. TWR114 and nonpathogenic Ralstonia sp. TCR112 to maximize biocontrol of tomato bacterial wilt, we tested combinations of TWR114 and TCR112. A combination of BCAs has improved biocontrol performance against several soil-borne diseases including bacterial wilt compared with either agent alone (Jetiyanon and Kloepper 2002; Liu et al. 2014; Roberts et al. 2005), but not in other cases (Harvás et al. 1997; Myresiotis et al. 2012). Our results clearly demonstrated that TWR114 + TCR112 treatment can exert a synergistic suppressive effect on the biocontrol of wilt disease. A single application of TWR114 + TCR112 achieved a more intense, prolonged biocontrol effect, lasting for at least 28 dpi, compared with less than 14 dpi with either TWR114 or TCR112 alone (Figs. 1, 2). Based on this result, the use of TWR114 and TCR112 together will allow the drenching frequency and total dosage of the isolates to be reduced to at least one-fourth of the individual applications. Moreover, TWR114 + TCR112 treatment did not adversely affect the growth of pathogen-uninoculated tomato plants even after 28 days (data not shown). Therefore, combined application of these two isolates should be cost-effective and practical.
Generally, biocontrol studies have tested multiple bacteria in a 1:1 mixture (Bardas et al. 2009; Jetiyanon and Kloepper 2002; Sundaramoorthy et al. 2012). Here, although the control by all TWR114 + TCR112 treatments was better than after individual treatments, the efficacy of the 1:1 TWR114 + TCR112 treatment was not the best; the 2:1 ratio was superior (Figs. 1, 2). These results suggest that the TWR114 isolate in this bacterial consortium should be higher to maximize the control of tomato bacterial wilt. However, the reason this specific ratio conferred the best biocontrol performance is still unclear. Similarly, Singh et al. (1999) showed that the combined application of Paenibacillus sp. Pb300 and Streptomyces sp. 385 was more effective against Fusarium wilt of cucumber than their individual application and that 4:1 and 3:2 ratios suppressed disease better than 1:4 and 2:3.
We tested several inoculum concentrations of TWR114 + TCR112 treatment at a 2:1 ratio for their biocontrol ability in the glasshouse. Although the original concentration (ca. 9 × 108 CFU/ml) gave the best biocontrol, the two lower concentrations (i.e., two- and tenfold diluted concentrations) also significantly reduced wilt incidence in a dose-dependent manner (Fig. 3). Therefore, we will evaluate the effectiveness of these different treatments in the field.
Roberts et al. (2005) defined compatible microbes as microbes that, when combined, do not have diminished disease suppression or reduced persistence in planta relative to the same isolates applied individually. Moreover, compatibility among BCAs in vitro is an important criterion for improved biocontrol (Dunne et al. 1998; Pierson and Weller 1994; Roberts et al. 2005). We found that TWR114 has in vitro antibacterial activity against TCR112, indicating that TWR114 is incompatible with TCR112 in vitro (Fig. 7). However, both isolates in the TWR114 + TCR112 treatment of plants established population densities at levels similar to those in the individual treatments (Figs. 5, 6). These data suggest that, although the combination of TWR114 and TCR112 was incompatible in vitro, it was not in planta. We previously found that TWR114 has antibacterial activity against the pathogenic Ralstonia (Marian et al. 2018) and thus assumed that TWR114 produces an antibacterial compound(s) that suppress Ralstonia species. However, in planta, TWR114 suppressed the population density of the pathogen only, while it did not affect that of TCR112 (Figs. 4, 6), indicating that the TWR114 isolate suppressed pathogen multiplication in tomato rhizosphere perhaps not via antibiosis-mediated antagonism but via other mechanisms such as competition for nutrients. Recently, Wu et al. (2017) showed that the competitive ability of BCAs to use certain components of tomato root exudates directly affected not only the population density of R. solanacearum but also its pathogenicity, thus efficiently suppressing the incidence of bacterial wilt.
The population of R. pseudosolanacearum in the rhizosphere and aboveground regions of tomato plant, particularly in the mid-stem and upper stem, was considerably decreased by the combined treatment of TWR114 and TCR112 compared with the levels after the individual treatments (Fig. 4). Interestingly, although the pathogen population in the aboveground regions of TWR114 + TCR112-treated plants increased to 2.4–4.8 log CFU/g fresh tissue at 7 dpi, its population decreased to an undetectable level (< 1.5 log CFU/g fresh tissue) at 28 dpi (Fig. 4b–d). This decrease may have been due to the enhanced defense responses after the TWR114 + TCR112 treatment. It was previously suggested that the priming of defense responses by treatment with the rhizobacterium Pseudomonas putida can reduce the population of R. solanacearum in root tissues of tomato plants (Ahn et al. 2011). Our results from the qRT-PCR analysis revealed that, after pathogen inoculation, the expression of several genes was induced by the TWR114 + TCR112 treatment and the corresponding individual treatments. However, both types of treatments showed varying levels of expression, in which the expression of most of these genes was more strongly induced in tomato plants treated with TWR114 + TCR112 than in those treated with the individual isolates, indicating an enhanced priming effect (Fig. 8). The importance of host defense priming in the suppression of several diseases caused by soil-borne pathogens, including bacterial wilt, by the treatment with beneficial microbes or some chemical elements such as silicon has already been reported (Aimé et al. 2013; Ghareeb et al. 2011; Jogaiah et al. 2013; Niu et al. 2012). Additionally, the greater induction of some defense-related enzymes has been suggested as a mechanism responsible for the enhanced biocontrol effect achieved by the combination of BCAs against bacterial wilt on tomato (Jetiyanon 2007) and tobacco (Yuan et al. 2016) plants.
Although the SA-dependent signaling pathway is involved in systemic acquired resistance and the JA- and ET-dependent signaling pathways are involved in the induction of systemic resistance (ISR) (Pieterse et al. 2009), recent evidence also suggests the partial involvement of an SA-dependent pathway during ISR in some cases (Niu et al. 2011). These signaling pathways do not work independently but instead influence one another through a complex network of synergistic and antagonistic interactions (Glazebrook 2005). Several studies have indicated that SA, JA, ET, and ABA signaling pathways are involved in the BCA-mediated ISR against bacterial wilt (Chen et al. 2009; Feng et al. 2012; Hase et al. 2006, 2008; Takahashi et al. 2014). In this study, the treatments with TWR114 or TCR112 alone resulted in priming for the enhanced expression of the ET-responsive marker genes GluB (coding a basic intracellular β-1,3-glucanase) and Osmotin-like, but only the TWR114 treatment boosted the expression of the ABA-regulated gene Le4 (coding a desiccation protective protein), suggesting that these two isolates might activate different signaling pathways. Interestingly, the expression of ET- and ABA-responsive marker genes was significantly more pronounced after the TWR114 + TCR112 treatment, and the expression of SA-regulated genes PR-1a and GluA (coding pathogenesis-related protein-1a and acidic extracellular β-1,3-glucanase, respectively) was primed only by this treatment (Fig. 8). Based on these findings, we propose that the TWR114 + TCR112-mediated ISR in tomato plants against the necrotrophic pathogen R. pseudosolanacearum may be due to the enhanced priming of SA-, ET-, and ABA-dependent defense responses. Recently, Alizadeh et al. (2013) showed that the combined application of Trichoderma harzianum and Pseudomonas sp. provided better disease suppression than their individual applications against Fusarium wilt of cucumber, mainly due to priming of both SA- and JA-dependent defense responses after pathogen inoculation. Further studies should thus aim at better understanding the involvement of the SA-, ET-, and ABA-dependent signaling pathways in the TWR114 + TCR112-mediated ISR by using tomato mutant lines impaired in the synthesis of these key defense-related hormones.
In conclusion, the findings from the present study clearly demonstrate that the combination of the biocontrol isolates Mitsuaria sp. TWR114 and nonpathogenic Ralstonia sp. TCR112 exerts a synergistic suppressive effect, resulting in enhanced biocontrol efficacy against tomato bacterial wilt. We established a cost-effective method for applying our isolates, which may support their future development and commercialization as new biocontrol products for controlling tomato bacterial wilt. More studies are still necessary to evaluate the effectiveness of the TWR114 + TCR112 treatment in the field.
References
Ahn IP, Lee SW, Kim MG, Park SR, Hwang DJ, Bae SC (2011) Priming by rhizobacterium protects tomato plants from biotrophic and necrotrophic pathogen infections through multiple defense mechanisms. Mol Cells 32:7–14
Aimé S, Alabouvette C, Steinberg C, Olivain C (2013) The endophytic strain Fusarium oxysporum Fo47: a good candidate for priming the defense responses in tomato roots. Mol Plant-Microbe Interact 26:918–926
Alizadeh H, Behboudi K, Ahmadzadeh M, Javan-Nikkhah M, Zamioudis C, Pieterse CMJ, Bakker PAHM (2013) Induced systemic resistance in cucumber and Arabidopsis thaliana by the combination of Trichoderma harzianum Tr6 and Pseudomonas sp. Ps14. Biol Control 65:14–23
Álvarez B, Biosca EG, López MM (2010) On the life of Ralstonia solanacearum, a destructive bacterial plant pathogen. In: Mendez-Vilas A (ed) Current research, technology and education topics in applied microbiology and microbial biotechnology. Formatex, Badajoz, pp 267–279
Bardas GA, Lagopodi AL, Kadoglidou K, Tzavella-Klonari K (2009) Biological control of three Colletotrichum lindemuthianum races using Pseudomonas chlororaphis PCL1391 and Pseudomonas fluorescens WCS365. Biol Control 49:139–145
Boukaew S, Chuenchit S, Petcharat V (2011) Evaluation of Streptomyces spp. for biological control of Sclerotium root and stem rot and Ralstonia wilt of chili pepper. BioControl 56:365–374
Chen YY, Lin YM, Chao TC, Wang JF, Liu AC, Ho FI, Cheng CP (2009) Virus-induced gene silencing reveals the involvement of ethylene-, salicylic acid- and mitogen-activated protein kinase-related defense pathways in the resistance of tomato to bacterial wilt. Physiol Plantarum 136:324–335
Chen D, Liu X, Li C, Tian W, Shen Q, Shen B (2014) Isolation of Bacillus amyloliquefaciens S20 and its application in control of eggplant bacterial wilt. J Environ Manage 137:120–127
Domenech J, Reddy MS, Kloepper JW, Ramos B, Gutierrez-Manero J (2006) Combined application of the biological product LS213 with Bacillus, Pseudomonas or Chryseobacterium for growth promotion and biological control of soil-borne diseases in pepper and tomato. Biocontrol 51:245–258
Dunne C, Moënne-Loccoz Y, McCarthy J, Higgins P, Powell J, Dowling DN, O’Gara F (1998) Combining proteolytic and phloroglucinol-producing bacteria for improved biocontrol of Pythium-mediated damping-off of sugar beet. Plant Pathol 47:299–307
Elphinstone JG (2005) The current bacterial wilt situation: a global overview. In: Allen C, Piror P, Hayward AC (eds) Bacterial wilt disease and the Ralstonia solanacearum. complex. APS Press, St. Paul, pp 9–28
Feng DX, Tasset C, Hanemian M, Barlet X, Hu J, Trémousaygue D, Deslandes L, Marco Y (2012) Biological control of bacterial wilt in Arabidopsis thaliana involves abscissic acid signalling. New Phytol 194:1035–1045
French ER, Gutarra L, Aley P, Elphinstone J (1995) Culture media for Pseudomonas solanacearum isolation, identification and maintenance. Fitopatologia 30:126–130
Ghareeb H, Bozsó Z, Ott PG, Repenning C, Stahl F, Wydra K (2011) Transcriptome of silicon-induced resistance against Ralstonia solanacearum in the silicon non-accumulator tomato implicates priming effect. Physiol Mol Plant Pathol 75:83–89
Glazebrook J (2005) Contrasting mechanisms of defense against biotrophic and necrotrophic pathogens. Annu Rev Phytopathol 43:205–227
Harvás A, Landa B, Jiménez-Díaz RM (1997) Influence of chickpea genotype and Bacillus sp. on protection from Fusarium wilt by seed treatment with nonpathogenic Fusarium oxysporum. Eur J Plant Pathol 103:631–642
Hase S, Shimizu A, Nakaho K, Takenaka S, Takahashi H (2006) Induction of transient ethylene and reduction in severity of tomato bacterial wilt by Pythium oligandrum. Plant Pathol 55:537–543
Hase S, Takahashi S, Takenaka S, Nakaho K, Arie T, Seo S, Ohashi Y, Takahashi H (2008) Involvement of jasmonic acid signalling in bacterial wilt disease resistance induced by biocontrol agent Pythium oligandrum in tomato. Plant Pathol 57:870–876
Hendrick CA, Sequeira L (1984) Lipopolysaccharide-defective mutants of the wilt pathogen Pseudomonas solanacearum. Appl Environ Microbiol 48:94–101
Jetiyanon K (2007) Defensive-related enzyme response in plants treated with a mixture of Bacillus strains (IN937a and IN937b) against different pathogens. Biol Control 42:178–185
Jetiyanon K, Kloepper JW (2002) Mixtures of plant growth-promoting rhizobacteria for induction of systemic resistance against multiple plant diseases. Biol Control 24:285–291
Jetiyanon K, Fowler WD, Kloepper JW (2003) Broad-spectrum protection against several pathogens by PGPR mixtures under field conditions in Thailand. Plant Dis 87:1390–1394
Jogaiah S, Abdelrahman M, Tran LS, Shin-ichi I (2013) Characterization of rhizosphere fungi that mediate resistance in tomato against bacterial wilt disease. J Exp Bot 64:3829–3842
Liu Y, Shi J, Feng Y, Yang X, Li X, Shen Q (2013) Tobacco bacterial wilt can be biologically controlled by the application of antagonistic strains in combination with organic fertilizer. Biol Fertil Soils 49:447–464
Liu HX, Li SM, Luo YM, Luo LX, Li JQ, Guo JH (2014) Biological control of Ralstonia wilt, Phytophthora blight, Meloidogyne root-knot on bell pepper by the combination of Bacillus subtilis AR12, Bacillus subtilis SM21 and Chryseobacterium sp. R89. Eur J Plant Pathol 139:107–116
Livak KJ, Schmittgen TD (2001) Analysis of relative gene expression data using real-time quantitative PCR and the 2–∆∆CT method. Methods 25:402–408
Lucas JA, Solano BR, Montes F, Ojeda J, Megias M, Mañero FG (2009) Use of two PGPR strains in the integrated management of blast disease in rice (Oryza sativa) in southern Spain. Field Crop Res 114:404–410
Mansfield J, Genin S, Magori S, Citovsky V, Sriariyanum M, Ronald P, Dow M, Verdier V, Beer SV, Machado MA, Toth I, Salmond G, Foster GD (2012) Top 10 plant pathogenic bacteria in molecular plant pathology. Mol Plant Pathol 13:614–629
Marian M, Nishioka T, Koyama H, Suga H, Shimizu M (2018) Biocontrol potential of Ralstonia sp. TCR112 and Mitsuaria sp. TWR114 against tomato bacterial wilt. Appl Soil Ecol 128:71–80
Martínez-Medina A, Fernández I, Sánchez-Guzmán MJ, Jung SC, Pascual JA, Pozo MJ (2013) Deciphering the hormonal signalling network behind the systemic resistance induced by Trichoderma harzianum in tomato. Front Plant Sci 4:206
Milling A, Babujee L, Allen C (2011) Ralstonia solanacearum extracellular polysaccharide is a specific elicitor of defense responses in wilt-resistant tomato plants. PLoS ONE 6:e15853
Myresiotis CK, Karaoglanidis GS, Vryzas Z, Papadopoulou-Mourkidou E (2012) Evaluation of plant-growth-promoting rhizobacteria, acibenzolar-S-methyl and hymexazol for integrated control of Fusarium crown and root rot on tomato. Pest Manag Sci 68:404–411
Niu DD, Liu HX, Jiang CH, Wang YP, Wang QY, Jin HL, Guo JH (2011) The plant growth-promoting rhizobacterium Bacillus cereus AR156 induces systemic resistance in Arabidopsis thaliana by simultaneously activating salicylate- and jasmonate/ethylene-dependent signaling pathways. Mol Plant-Microbe Interact 24:533–542
Niu DD, Wang CJ, Guo YH, Jiang CH, Zhang WZ, Wang YP, Guo JH (2012) The plant growth-promoting rhizobacterium Bacillus cereus AR156 induces resistance in tomato with induction and priming of defence response. Biocontrol Sci Technol 22:991–1004
Pierson EA, Weller DM (1994) Use of mixtures of fluorescent pseudomonads to suppress take-all and improve the growth of wheat. Phytopathology 84:940–947
Pieterse CM, Leon-Reyes A, Van der Ent S, Van Wees SC (2009) Networking by small-molecule hormones in plant immunity. Nat Chem Biol 5:308–316
Raupach GS, Kloepper JW (1998) Mixtures of plant growth-promoting rhizobacteria enhance biological control of multiple cucumber pathogens. Phytopathology 88:1158–1164
Roberts DP, Lohrke SM, Meyer SL, Buyer JS, Bowers JH, Baker CJ, Li W, de Souza JT, Lewis JA, Chung S (2005) Biocontrol agents applied individually and in combination for suppression of soilborne diseases of cucumber. Crop Protect 24:141–155
Safni I, Cleenwerck I, De Vos P, Fegan M, Sly L, Kappler U (2014) Polyphasic taxonomic revision of the Ralstonia solanacearum species complex: proposal to emend the descriptions of Ralstonia solanacearum and Ralstonia syzygii and reclassify current R. syzygii strains as Ralstonia syzygii subsp. syzygii subsp. nov., R. solanacearum phylotype IV strains as Ralstonia syzygii subsp. indonesiensis subsp. nov., banana blood disease bacterium strains as Ralstonia syzygii subsp. celebesensis subsp. nov. and R. solanacearum phylotype I and III strains as Ralstonia pseudosolanacearum. Int J Syst Evol Microbiol 64:3087–3103
Santiago CD, Yagi S, Ijima M, Nashimoto T, Sawada M, Ikeda S, Asano K, Orikasa Y, Ohwada T (2017) Bacterial compatibility in combined inoculations enhances the growth of potato seedlings. Microbes Environ 32:14–23
Sarma BK, Yadav SK, Singh S, Singh HB (2015) Microbial consortium-mediated plant defense against phytopathogens: readdressing for enhancing efficacy. Soil Biol Biochem 87:25–33
Singh PP, Shin YC, Park CS, Chung YR (1999) Biological control of Fusarium wilt of cucumber by chitinolytic bacteria. Phytopathology 89:92–99
Singh R, Soni SK, Kalra A (2013) Synergy between Glomus fasciculatum and a beneficial Pseudomonas in reducing root diseases and improving yield and forskolin content in Coleus forskohlii Briq. under organic field conditions. Mycorrhiza 23:35–44
Spadaro D, Gullino ML (2005) Improving the efficacy of biocontrol agents against soilborne pathogens. Crop Protect 24:601–613
Srivastava R, Khalid A, Singh US, Sharma AK (2010) Evaluation of arbuscular mycorrhizal fungus, fluorescent Pseudomonas and Trichoderma harzianum formulation against Fusarium oxysporum f. sp. lycopersici for the management of tomato wilt. Biol Control 53:24–31
Sundaramoorthy S, Raguchander T, Ragupathi N, Samiyappan R (2012) Combinatorial effect of endophytic and plant growth promoting rhizobacteria against wilt disease of Capsicum annum L. caused by Fusarium solani. Biol Control 60:59–67
Suzuki Y, Hibino T, Kawazu T, Wada T, Kihara T, Koyama H (2003) Extraction of total RNA from leaves of Eucalyptus and other woody and herbaceous plants using sodium isoascorbate. Biotechniques 34:988–993
Takahashi H, Nakaho K, Ishihara T, Ando S, Wada T, Kanayama Y, Asano S, Yoshida S, Tsushima S, Hyakumachi M (2014) Transcriptional profile of tomato roots exhibiting Bacillus thuringiensis-induced resistance to Ralstonia solanacearum. Plant Cell Rep 33:99–110
Wu K, Su L, Fang Z, Yuan S, Wang L, Shen B, Shen Q (2017) Competitive use of root exudates by Bacillus amyloliquefaciens with Ralstonia solanacearum decreases the pathogenic population density and effectively controls tomato bacterial wilt. Sci Hort 218:132–138
Xu XM, Jeffries P, Pautasso M, Jeger MJ (2011) Combined use of biocontrol agents to manage plant diseases in theory and practice. Phytopathology 101:1024–1031
Xue QY, Chen Y, Li SM, Chen LF, Ding GC, Guo DW, Guo JH (2009) Evaluation of the strains of Acinetobacter and Enterobacter as potential biocontrol agents against Ralstonia wilt of tomato. Biol Control 48:252–258
Yabuuchi E, Kosako Y, Yano I, Hotta H, Nishiuchi Y (1995) Transfer of two Burkholderia and an Alcaligenes species to Ralstonia gen. nov.: proposal of Ralstonia pickettii (Ralston, Palleroni and Doudoroff 1973) comb. nov., Ralstonia solanacearum (Smith 1896) comb. nov. and Ralstonia eutropha (Davis 1969) comb. nov. Microbiol Immunol 39:897–904
Yamamoto S, Shiraishi S, Kawagoe Y, Mochizuki M, Suzuki S (2015) Impact of Bacillus amyloliquefaciens S13-3 on control of bacterial wilt and powdery mildew in tomato. Pest Manag Sci 71:722–727
Yuan S, Li M, Fang Z, Liu Y, Shi W, Pan B, Wu K, Shi J, Shen B, Shen Q (2016) Biological control of tobacco bacterial wilt using Trichoderma harzianum amended bioorganic fertilizer and the arbuscular mycorrhizal fungi Glomus mosseae. Biol control 92:164–171
Yuliar NA, Toyota K (2015) Recent trends in control methods for bacterial wilt diseases caused by Ralstonia solanacearum. Microbes Environ 30:1–11
Acknowledgements
This work was financially supported by JSPS KAKENHI (Grant Numbers JP24780317 and JP15KT0029).
Author information
Authors and Affiliations
Corresponding author
Rights and permissions
About this article
Cite this article
Marian, M., Morita, A., Koyama, H. et al. Enhanced biocontrol of tomato bacterial wilt using the combined application of Mitsuaria sp. TWR114 and nonpathogenic Ralstonia sp. TCR112. J Gen Plant Pathol 85, 142–154 (2019). https://doi.org/10.1007/s10327-018-00834-6
Received:
Accepted:
Published:
Issue Date:
DOI: https://doi.org/10.1007/s10327-018-00834-6